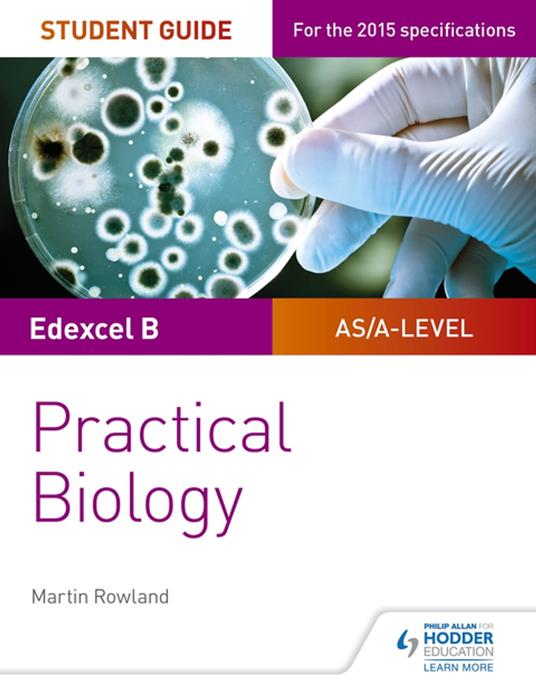
Edexcel A-level Biology Student Guide: Practical Biology

Edexcel A-level Biology Student Guide: Practical Biology
Exam Board: Edexcel Level: AS/A-level Subject: Biology First Teaching: September 2015 First Exam: June 2016 Ensure your students get to grips with the core practicals and develop the skills needed to succeed with an in-depth assessment-driven approach that builds and reinforces understanding; clear summaries of practical work with sample questions and answers help to improve exam technique in order to achieve higher grades. Written by experienced teacher Martin Rowland, this Student Guide for practical Biology: - Help students easily identify what they need to know with a concise summary of required practical work examined in the A-level specifications. - Consolidate understanding of practical work, methodology, mathematical and other skills out of the laboratory with exam tips and knowledge check questions, with answers in the back of the book. - Provide plenty of opportunities for students to improve exam technique with sample answers, examiners tips and exam-style questions. - Offer support beyond the Student books with coverage of methodologies and generic practical skills not focused on in the textbooks.
-
Autore:
-
Anno edizione:2017
-
Editore:
-
Formato:
-
Lingua:Inglese
Formato:
Gli eBook venduti da Feltrinelli.it sono in formato ePub e possono essere protetti da Adobe DRM. In caso di download di un file protetto da DRM si otterrà un file in formato .acs, (Adobe Content Server Message), che dovrà essere aperto tramite Adobe Digital Editions e autorizzato tramite un account Adobe, prima di poter essere letto su pc o trasferito su dispositivi compatibili.
Cloud:
Gli eBook venduti da Feltrinelli.it sono sincronizzati automaticamente su tutti i client di lettura Kobo successivamente all’acquisto. Grazie al Cloud Kobo i progressi di lettura, le note, le evidenziazioni vengono salvati e sincronizzati automaticamente su tutti i dispositivi e le APP di lettura Kobo utilizzati per la lettura.
Clicca qui per sapere come scaricare gli ebook utilizzando un pc con sistema operativo Windows